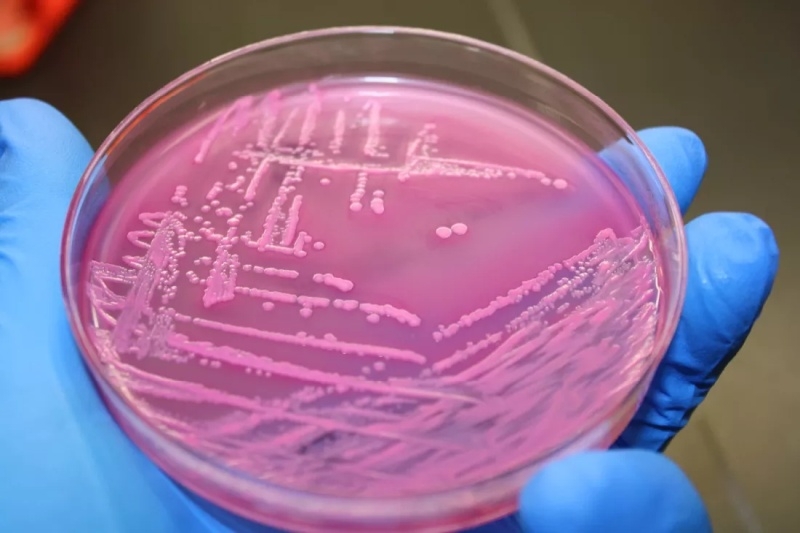
Учёные нашли альтернативную эволюцию&nbsp;&mdash; в космосе бактерии и вирусы развиваются иначе

Контролируемый эксперимент на борту Международной космической станции (МКС) показал, что в космосе микроскопическая жизнь подчиняется иным законам и даже простая вирусная инфекция протекает по-другому. Когда бактерии и вирусы-фаги взаимодействуют в условиях микрогравитации, оба организма эволюционируют новыми способами, не наблюдаемыми на Земле. Понимание того, как микробы адаптируются в этой среде, может дать учёным новую основу для разработки биотехнологий.

Итоги 2025 года: программное обеспечение

Итоги 2025 года: процессоры для ПК

Лучшие игры 2025 года: выбор читателей и редакции

Лучшие ИИ-сервисы и приложения 2025 года: боты одолевают

Итоги 2025 года: интернет-индустрия

Итоги 2025 года: смартфоны

Итоги 2025-го: ИИ-лихорадка, рыночные войны, конец эпохи Windows 10 и ещё 12 главных событий года

Итоги 2025 года: носимые устройства

Обзор ноутбука TECNO MEGABOOK S14 (S14MM): OLED с HDR как новая норма

Итоги 2025 года: игровые видеокарты

Итоги 2025 года: почему память стала роскошью и что будет дальше

Результаты, опубликованные в журнале PLOS Biology, получены исследователями из Университета Висконсина в Мэдисоне. Они изучили взаимодействие между кишечной палочкой (Escherichia coli, E. coli) и инфицирующим её вирусом — бактериофагом T7. Идентичные образцы параллельно культивировались как на Земле, так и на орбите, чтобы понять, как отсутствие гравитации влияет на циклы заражения, скорость мутаций и стратегии выживания.
На Земле жидкости, содержащие микробы, постоянно перемешиваются конвекцией – тёплые области поднимаются, холодные опускаются. Это движение способствует частым столкновениям вирусов и бактерий, ускоряя инфекцию и размножение. Однако в условиях микрогравитации эти привычные потоки исчезают. Без гравитационного перемешивания всё остаётся в подвешенном состоянии — взаимодействия зависят лишь от медленного молекулярного дрейфа, а не от естественного движения жидкости.
Исследовательская группа обнаружила, что, хотя фаги на борту МКС все ещё могли инфицировать кишечную палочку, этот процесс протекал гораздо медленнее. Меньшее количество столкновений заставило как бактерии, так и вирусы адаптироваться. Фаги начали оптимизировать свою способность прикрепляться к клеткам, с которыми они сталкивались, в то время как бактерии тонко настраивали поверхностные рецепторы, чтобы противостоять этим же атакам. Замедленная, но непрерывная борьба изменила генетический ландшафт обоих организмов.
Полногеномное секвенирование показало, что в образцах с МКС развились уникальные мутации, отсутствующие в контрольной группе на Земле. Фаги, появившиеся в космосе, накопили генетические изменения, которые повысили их способность связываться с бактериальными рецепторами, в то время как кишечная палочка изменила гены, участвующие в работе этих рецепторов, чтобы противостоять вирусной атаке.
Исследователи использовали глубокое мутационное сканирование — высокоточный метод картирования эффектов тысяч мутаций — чтобы отследить, как эти изменения перестраивают белки, связывающие рецепторы фагов. Эта молекулярная перестройка имела неожиданный эффект. Когда эволюционировавшие в космосе фаги были позже протестированы на Земле, они оказались более эффективными против штаммов кишечной палочки, вызывающих инфекции мочевыводящих путей — патогенов, часто устойчивых к стандартным фагам Т7.

Хотя по словам руководителя исследования Сриватсана Рамана (Srivatsan Raman) это открытие стало случайным, его последствия выходят далеко за пределы МКС. Наблюдения за эволюцией в замедленной среде демонстрируют, как вирусы манипулируют своим генетическим кодом в ограниченных условиях. Эта информация может лечь в основу новых стратегий разработки фаговых терапевтических средств — специально созданных вирусов, нацеленных на бактерии, устойчивые к антибиотикам.
По мнению исследователей, главным практическим препятствием подобных экспериментов остаётся их высокая стоимость, но результаты могут улучшить методы лечения земных инфекций и повысить медицинские меры безопасности для астронавтов, находящихся в длительных миссиях на Луну или Марс.



Добавить комментарий